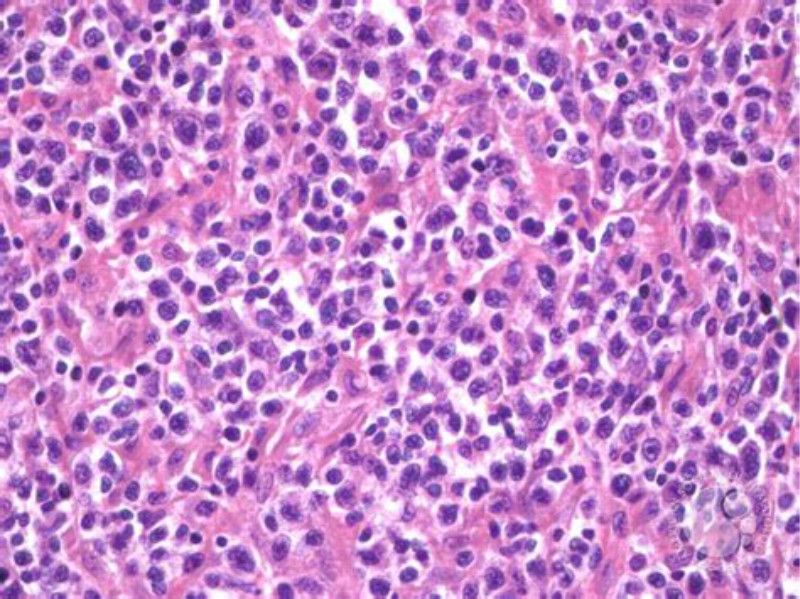
t细胞淋巴瘤

T细胞淋巴瘤

汪旸副教授课题组建立皮肤t细胞淋巴瘤新的分子分型体系转载
图片尺寸694x448
皮肤t细胞淋巴瘤的组织学与临床(陈浩~中山大学一附院)
图片尺寸2667x2000
外周t细胞淋巴瘤
图片尺寸1268x951
皮肤t细胞淋巴瘤的组织学与临床(陈浩~中山大学一附院)
图片尺寸2667x2000
看图识病:皮肤 t 淋巴细胞瘤一例 --生命经纬
图片尺寸640x478
一例血管免疫母细胞性t细胞淋巴瘤病例分享
图片尺寸412x588
肝脾t细胞淋巴瘤_骨髓
图片尺寸1080x810
我爸诊断出外周t细胞淋巴瘤非特指各位大佬能帮我看看吗
图片尺寸397x561
肝脾t细胞淋巴瘤_骨髓
图片尺寸1080x810
外周t细胞淋巴瘤,非特指型
图片尺寸1616x1216
看图识病:皮肤 t 淋巴细胞瘤一例
图片尺寸500x372
t细胞淋巴瘤
图片尺寸800x599
73岁男性患外周t细胞淋巴瘤入院治疗病例分析
图片尺寸559x303
nejm:结外nk/t细胞淋巴瘤1例_医学资讯_大夫e站
图片尺寸486x492
手臂肿物----结外nk/t细胞性淋巴瘤
图片尺寸600x450
鼻型nk/t细胞淋巴瘤1例
图片尺寸1517x2024
一例2型肠病相关t细胞淋巴瘤eatl病例分析
图片尺寸750x417
血管免疫母t细胞淋巴瘤
图片尺寸1268x951
这是t细胞淋巴瘤吗
图片尺寸780x1040
"120万一针"car-t细胞疗法,让复发难治淋巴瘤有治愈希望__财经头条
图片尺寸428x323